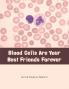
Blood Cells Are Your Best Friends Forever

English
Paperback
₹2564
₹3069
16.45% OFF
(All inclusive*)
Delivery Options
Please enter pincode to check delivery time.
*COD & Shipping Charges may apply on certain items.
Review final details at checkout.
Looking to place a bulk order? SUBMIT DETAILS
About The Book
Description
Author
This Book Is Aimed At Young People (Ages Twelve And Older).It Describes Each Of The Blood Cells Or Formed Elements In Blood Using Cartoons As Illustrations. Each Cell Is Described As To Its Appearance Its Function Or Job How It Does Its Job Where It Came From What Can Go Wrong And What The Reader Can Do To Help.
Delivery Options
Please enter pincode to check delivery time.
*COD & Shipping Charges may apply on certain items.
Review final details at checkout.
Details
ISBN 13
9781504933797
Publication Date
-10-09-2015
Pages
-58
Weight
-162 grams
Dimensions
-216x280x4 mm